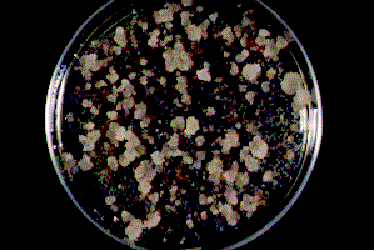

成績概要書(2002年1月作成)
研究課題:てんさい形質転換法の開発
担当部署:中央農試 農産工学部 細胞育種科,遺伝子工学科
協力分担:
予算区分:共同
研究期間:1998〜2000年度
|
1.目 的
てんさいにおいて各種遺伝子の発現解析を行うには,安定した形質転換系が必要である。
カルスからの植物体再分化能の高いてんさい系統を見いだしたことから,この系統を利用して,
アグロバクテリウム法による効率的,安定的な形質転換法を開発する。
2.方 法
1)供試材料
北海道農業研究センター育成のてんさい自殖系統「NK-219mm-O」の数個体
2)供試菌株およびベクター
ビアラホス耐性(bar)遺伝子およびカナマイシン抵抗性(NPTⅡ)遺伝子を組み込んだバイナリー
ベクターpARK5を保持するアグロバクテリウム系統 LBA4404 (明治製菓(株)より分譲)
3)てんさい形質転換法の確立
葉片カルスを0.25mg/l BAPを含む修正MS液体培地に移植し,液体懸濁培養細胞を誘導した。
7〜10日後,0.5gを新しい液体培地に継代した。継代数日後,アセトシリンゴンおよび
アグロバクテリウム培養液を添加して,数日間共存培養を行った。アグロバクテリウムを洗浄後,
懸濁培養細胞をビアラホス耐性カルスの選抜のために2mg/l ビアラホス,
500mg/l カルベニシリン(あるいはスルベニシリン)を含む選抜培地上に展開した。約1ヶ月後,
肥大したカルスを2mg/l ビアラホスを含む不定胚形成培地に移植し,5〜7週間後,得られた
不定胚を植物ホルモン無添加の培地に置床した。さらに数回同組成の培地に継代し,健全植物体を得た。
4)形質転換効率の向上
耐性カルス形成率に関わると思われる,共存培養時の①開始までの継代後日数,②期間,
③アグロバクテリウム培養液量,④アセトシリンゴン濃度について検討。
5)導入遺伝子の存在および発現の確認
再分化個体のPCR法によるビアラホス耐性遺伝子の確認およびビアラホス添加培地での葉片培養
によるビアラホス耐性検定。
3.成果の概要
1)てんさいの効率的な形質転換法を明らかにした。葉片カルスより誘導した液体懸濁培養細胞に,
ビアラホス耐性遺伝子をもつアグロバクテリウムを感染させ,ビアラホスにより選抜することで,
耐性カルス(図1),さらには再分化植物体が得られた(図2)。
2)三角フラスコ1本分の懸濁培養細胞より得られるビアラホス耐性カルス形成数は,継代4日後の
懸濁培養細胞に,アグロバクテリウム培養液0.1mlおよび100mg/l アセトシリンゴンを添加し,
3〜4日間共存培養したとき,最も多くなった(表1,表2)。
3)ビアラホス耐性カルスの約38%(5回の実験の平均)が不定胚を形成し,不定胚を形成したカルスの
半数が再分化植物体を形成した。
4)再分化植物体は,葉片をビアラホスを含むカルス形成培地に置床すると旺盛にカルスを形成し(図3),
また,PCR法による導入遺伝子の確認により(図4),形質転換体であることが明らかになった。
表1 ビアラホス耐性カルスの形成に及ぼす共存培養開始時期の影響
実験 No. |
個体 No. |
共存培養開始時期(継代後日数) |
| 2日 |
3日 |
4日 |
5日 |
6日 |
| 1 |
P16 |
1221) |
162 |
274 |
721 |
ND |
| 2 |
P17 |
53 |
35 |
131 |
ND |
ND |
| 3 |
P10 |
98 |
211 |
339 |
611 |
ND |
| 4 |
P36 |
55 |
91 |
65 |
ND |
ND |
| 平均 |
82 |
125 |
202 |
-666 |
ND |
1) 三角フラスコ1本分の懸濁培養細胞より得られた耐性カルス数。
NDはカルスが盛り上がり,計測不能。
表2 ビアラホス耐性カルスの形成に及ぼす共存培養期間の影響
実験 No. |
個体 No. |
共存培養 開始時期 |
共存培養期間 |
| 1日 |
2日 |
3日 |
4日 |
5日 |
| 1 |
P22 |
4日後 |
01) |
19 |
103 |
396 |
603 |
| 2 |
P6 |
5日後 |
0 |
117 |
543 |
ND |
ND |
| 3 |
P16 |
4日後 |
0 |
32 |
274 |
458 |
ND |
| 4 |
P17 |
4日後 |
0 |
13 |
38 |
93 |
ND |
| 平均 |
0 |
45 |
240 |
-316 |
-603 |
1)三角フラスコ1本分の懸濁培養細胞より得られた耐性カルス数。
NDはカルスが盛り上がり,計測不能。
図1 ビアラホス耐性カルスの形成

図2 てんさい形質転換の手順

図3 葉片培養によるビアラホス耐性検定

図4 PCR法による導入遺伝子の確認
M:サイズマーカー,C:非形質転換体
1〜22:形質転換体
4.成果の活用面と留意点
1)形質転換効率が高いことから,てんさいにおける各種遺伝子の発現と機能解析を効率的に
行うことが出来る。
2)この形質転換法は,カルスからの植物体再分化能の高い系統「NK-219mm-O」を材料に,
ビアラホス耐性遺伝子を選抜マーカー遺伝子として用いている。
5.残された問題とその対応
1)後代種子の採種と導入遺伝子の遺伝性確認。